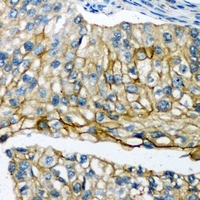
Rabbit Polyclonal Antibody to POTEG

提醒成功

搜索
Rabbit Polyclonal Antibody to POTEG
-
货号:
P43620 -
别名:
POTEG; A26C2; POTE14; POTE ankyrin domain family member G; ANKRD26-like family C member 2; Prostate ovary testis-expressed protein on chromosome 14; POTE-14; POTEH; A26C3; ACTBL1; POTE22; POTE ankyrin domain family member H; ANKRD26-like family C member 3; Prostate ovary testis-expressed protein on chromosome 22; POTE-22; POTEM; Putative POTE ankyrin domain family member M -
应用:
WB,IHC -
反应种属:
Human,Mouse,Rat -
抗体类型:
Primary antibody -
Swissprot:
Q6S5H5 -
规格:
-
数量:
-+ -
说明书:
目录价¥1980

Rabbit Polyclonal Antibody to POTEG
Specification |
|
|---|---|
| Aliases | POTEG; A26C2; POTE14; POTE ankyrin domain family member G; ANKRD26-like family C member 2; Prostate ovary testis-expressed protein on chromosome 14; POTE-14; POTEH; A26C3; ACTBL1; POTE22; POTE ankyrin domain family member H; ANKRD26-like family C member 3; Prostate ovary testis-expressed protein on chromosome 22; POTE-22; POTEM; Putative POTE ankyrin domain family member M |
| Entrez GeneID | 404785; |
| Swissprot | Q6S5H5 |
| WB Predicted band size | 57,54kDa |
| Host/Isotype | Rabbit IgG |
| Antibody Type | Primary antibody |
| Storage | Store at 4°C short term. Aliquot and store at -20°C long term. Avoid freeze/thaw cycles. |
| Species Reactivity | Human,Mouse,Rat |
| Immunogen | KLH-conjugated synthetic peptide encompassing a sequence within the C-term region of human POTEG. |
| Formulation | Liquid in PBS containing 50% glycerol, 0.5% BSA and 0.02% sodium azide. |
Application |
|
|---|---|
| WB | 1/500-1/1000 |
| IHC | 1/50-1/100 |
Product Image
- Western blot analysis of Panopsin expression in Hela, A431, mouse brain whole cell lysates.
- Immunohistochemical analysis of POTEG staining in human prostate cancer formalin fixed paraffin embedded tissue section. The section was then incubated with the antibody at room temperature and detected using an HRP conjugated compact polymer system. DAB was used as the chromogen. The section was then counterstained with haematoxylin and mounted with DPX.
For Reseach Only
Application Key:WB - Western Blot | IHC - Immunohistochemistry | ICC - Immunocytochemistry | FCM - Flow Cytometry | ELISA - Enzyme-linked Immunosorbent Assay | IP - Immunoprecipitation
#P43620

相关产品















 微信/QQ登录
微信/QQ登录


 首页
首页